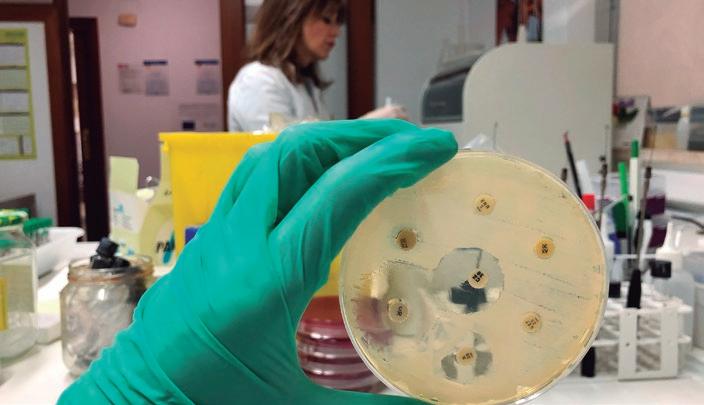

14 minute read
Piensos funcionales con posbióticos como una novedosa estrategia para la reducción de antibióticos
from Suis 181
by Grupo Asís
nutrición
Piensos funcionales con posbióticos como una novedosa estrategia para la reducción de antibióticos
Resumen
María Bravo1 y Javier Blanco2
1Veterinaria e investigadora en Ingulados. 2Farmacéutico e investigador en Ingulados. Fotos cedidas por los autores
Contacto con la autora: María Bravo: maria@ingulados.com La suplementación con piensos funcionales trae consigo mejoras considerables para los animales de producción. Por un lado, un mejor estado de salud tiene como consecuencia directa un mayor crecimiento y una menor mortalidad durante las fases críticas de la producción y, por otra parte, la acción antibacteriana debida a los compuestos bioactivos presentes en estos piensos, representan una herramienta de gran potencial para hacer frente a las infecciones debidas a bacterias patógenas. Los posbióticos son subproductos metabólicos producidos por microorganismos probióticos, como las bacterias ácido-lácticas, que son generados bajo condiciones específicas y añadidos al pienso animal sin alterar los parámetros dietéticos. Los piensos funcionales con posbióticos constituyen una de las alternativas a los antibióticos con mayor potencial en la actualidad.
Palabras clave: piensos funcionales, posbióticos, nutrición animal.
Abstract
Functional feed with postbiotics as a new strategy to reduce antibiotics
Supplementation with functional feed brings considerable improvements for animal production management. On the one hand, a good health status poses a direct impact on the growth during the critical phases of production. On the other hand, the antibacterial action due to the bioactive compounds present in these feeds, represent a tool to deal with infections caused by pathogenic bacteria. Postbiotics are metabolic by-products produced by probiotic microorganisms, such as lactic acid bacteria, which are generated under specific conditions and added to animal feed without altering the dietary parameters. Functional feeds with postbiotics are considered to be one of the alternatives to antibiotics with major potential nowadays.
Keywords: functional feed, postbiotics, animal nutrition.
El sector ganadero ha sufrido importantes transformaciones y ha ido progresando de forma exponencial durante las últimas décadas, siendo el sector que más crecimiento ha experimentado dentro de la economía agrícola. La ganadería aporta un 40 % del valor de la producción agrícola global y representa el principal medio de subsistencia de casi 1.300 millones de personas en todo el mundo. El crecimiento poblacional y económico ha favorecido la intensificación en la producción ganadera como respuesta al incremento en la demanda de productos de origen animal.
NECESIDAD DE ALTERNATIVAS A LOS ANTIBIÓTICOS
Estos hechos han traído aparejados dos graves problemas relacionados con la Salud Pública. Por una parte, la administración de antibióticos en dosis subterapéuticas como promotores del crecimiento para aumentar los indicadores productivos de los animales es una de las principales causas de aparición y diseminación de resistencias antimicrobianas, lo que ocasionó la prohibición de esta práctica en todos los países de la Unión Europea en el año 2006. Por otra parte, la emergencia de las enfermedades zoonóticas transmitidas a través de los alimentos de origen animal, denominadas “toxiinfecciones alimentarias”, continúan siendo una seria amenaza para la Salud Pública y además causan importantes pérdidas económicas en las producciones a nivel mundial. En este contexto, surge la necesidad de buscar alternativas a la administración de antimicrobianos como promotores del crecimiento que permitan satisfacer el incremento en la demanda de productos de origen animal, sin comprometer la salud de estos y de las personas. Estas alternativas deben ser sostenibles, mejorar los indicadores productivos de los animales y, sobre todo, su salud, la salud medioambiental y, con ello, la salud humana bajo la estrategia global “One Health” (figura 1).

LA IMPORTANCIA DEL EQUILIBRIO GASTROINTESTINAL
Los seres vivos absorben nutrientes a través de las barreras presentes en el tracto gastrointestinal, conformado por distintas secciones con diferentes funciones, enfocadas a la digestión de los alimentos, absorción de nutrientes y desechando aquellas sustancias que no reporten beneficio alguno, así como aquellas que pudiesen ser perjudiciales o tóxicas. Este sistema se encuentra en fino equilibrio, fundamental para la salud del organismo; cuando este sistema se ve alterado son muy numerosas las repercusiones negativas sobre la fisiología del organismo, lo que repercute enormemente sobre la salud del mismo. Una de las alteraciones de mayor relevancia que se producen cuando se establece un desequilibrio en el sistema gastrointestinal son las alteraciones de tipo inmunológico, que pueden acarrear graves consecuencias, tales como una elevada recurrencia de enfermedades infecciosas o de tipo autoinmunitario, así como un desarrollo insuficiente en el crecimiento. La salud gastrointestinal está íntimamente relacionada con los microorganismos que habitan en el aparato digestivo, especialmente en las últimas porciones del intestino. Estos microorganismos han evolucionado a lo largo de los tiempos paralelamente con su hospedador, estableciéndose una relación simbiótica fundamental para mantener el equilibrio del sistema gastrointestinal. A estos microorganismos que habitan sobre las superficies de otros seres vivos se les conoce como Microbiota.
INFLUENCIA DE LA MICROBIOTA SOBRE LA SALUD
Todos los seres vivos poseen una microbiota específica indispensable para el correcto desarrollo de sus funciones vitales y que está profundamente adaptada a la vida en sus respectivos hospedadores y superficies como son la piel y las mucosas genitourinaria, respiratoria e intestinal, siendo especialmente importante la intestinal por el número y diversidad de poblaciones bacterianas. La microbiota intestinal realiza funciones tales como la digestión de nutrientes no digeribles por su hospedador, defensa contra microorganismos patógenos y modulación de funciones fisiológicas tales como la respuesta inmunitaria (figura 2). El término que hace referencia a situación en la que existe un equilibrio entre las poblaciones que conforman la microbiota es “eubiosis” y está íntimamente relacionado con la función normal intestinal. Bajo determinadas condiciones como el estrés, una mala alimentación, una infección por bacterias patógenas o un tratamiento
Salud humana
Figura 1. One Health, una sola salud.
Salud ambiental
Una sola salud
Salud animal
nutrición
con antibióticos, entre otras, se produce un desequilibrio en las poblaciones que conforman la microbiota, perdiendo el estado de eubiosis, lo que recibe el nombre de “disbiosis”. La disbiosis trae consigo alteraciones fisiológicas que debilitan el estado de salud del hospedador y que lo hacen más vulnerable al desarrollo de numerosas patologías, tales como infección por patógenos o desarrollo de procesos inflamatorios que repercuten sobre toda la fisiología del organismo, de ahí la necesidad de recuperar el equilibrio entre los microorganismos comensales beneficiosos para lograr una buena función del sistema gastrointestinal. Los factores estresantes relacionados con el manejo de los animales de producción pueden alterar la composición y las importantes funciones de la microbiota, lo que resulta en una disbiosis que tiene consecuencias negativas para la salud animal. De hecho, cada vez existe una mayor evidencia científica del papel importante que tiene la microbiota del tracto gastrointestinal en la rentabilidad de los animales de producción. Por todo esto, se ha incrementado la necesidad de mitigar los problemas asociados a la intensificación de la producción ganadera, como ocurre en la etapa de cebo de los animales, que consigan aumentar los aspectos relacionados con el bienestar animal sin ocasionar un detrimento de los parámetros productivos de los animales y respetando la normativa actual en materia de aditivos promotores del crecimiento.
EFECTO BENEFICIOSO DE LOS PROBIÓTICOS SOBRE LA MICROBIOTA
En las últimas décadas se ha puesto el punto de mira en el uso de microorganismos beneficiosos para el control y recuperación de la salud gastrointestinal. Estos microorganismos beneficiosos reciben el nombre de “probióticos” y vienen definidos por la Organización Mundial de la Salud como: “microorganismos vivos que, administrados en dosis adecuadas, reportan un beneficio para la salud del hospedador”. Su mecanismo de acción es similar al de los microorganismos presentes en una microbiota sana: repoblando superficies afectadas, impidiendo la adhesión de patógenos y modulando la respuesta inmunitaria, entre otras. La influencia que ejercen sobre la función fisiológica del hospedador se debe a las moléculas que generan como fruto de su metabolismo y a aquellas que conforman sus estructuras celulares, que actúan sobre receptores celulares específicos presentes en el hospedador. El uso de los probióticos para mejorar la salud es algo que se lleva utilizando desde años, sea en salud humana como en veterinaria, pero los mecanismos que se esconden detrás de su uso es algo que se encuentra en la vanguardia de la ciencia. En los últimos años, la evidencia científica que hace referencia a estos mecanismos ha aumentado considerablemente, dejando claro el creciente interés sobre los probióticos y su mecanismo de acción, lo que permite una mejor caracterización de las especies bacterianas y de cómo realizan su función en el organismo. Cada cepa bacteriana posee un perfil metabólico único y tiene unas características estructurales distintas al del resto de bacterias. Esta diferencia en el perfil metabólico entre cepas de probióticos permite establecer un patrón sobre la composición molecular de cada bacteria y asociarlo a la actividad que tengan sus componentes. Gracias a los estudios sobre sus componentes y su mecanismo de acción sobre la fisiología de los hospedadores, se puede asociar a las diferentes bacterias, según su perfil metabólico, con
Nutrientes
Figura 2. Principales funciones de la microbiota intestinal (Adaptado de Biocodex-Microbiota Institute)
Toxinas, microbios Células de defensa intestinal
Mucosa intestinal
Microbiota intestinal
1 Función metabólica
Favorecer la digestión de ingredientes no digeribles.
Compuestos antimicrobianos

2 Función de barrera
Producción de compuestos antimicrobianos para evitar la colonización de microorganismos patógenos.
3 Función de defensa
Desarrollo de sistema inmunitario intestinal y producción de moco protector. Células del intestino
4 Función de mantenimiento
Maduración del tubo digestivo, promotor de la mucosa intestinal y la actividad enzimática.
repercusiones directas sobre la salud de los mismos y abre la puerta a tratamientos en base a sus cualidades terapéuticas. Los probióticos tienen muchas ventajas para la salud de los hospedadores pero presentan limitaciones tecnológicas como su almacenamiento. Una alternativa a estas limitaciones es el uso de posbióticos, que se definirá más adelante. La estrecha relación entre la microbiota y el hospedador que se ha ido desarrollando tras años de coevolución ha llevado a la integración de rutas metabólicas e inmunológicas entre ambos, estableciéndose una relación simbiótica. Los posbióticos son un conglomerado de moléculas derivadas de los probióticos y de los productos de su metabolismo que actúan sobre estas rutas, generando una respuesta controlada y predecible sobre el organismo al que son administrados.
PIENSOS FUNCIONALES CON POSBIÓTICOS

En la actualidad, el empleo de aditivos funcionales en nutrición animal es la principal opción para mejorar los índices productivos, prevenir la aparición de enfermedades y respetar el bienestar animal. En este sentido, entendemos como “piensos funcionales” a los piensos para alimentación animal suplementados con compuestos bioactivos que, incorporados a la dieta de los animales, pueden mejorar su bienestar y productividad más allá de lo que cabría esperar o explicar por su simple potencial nutricional. Entre los componentes bioactivos más utilizados en alimentación animal, los compuestos de la familia de los “-bióticos” son los más utilizados. Tanto los “prebióticos”, ingredientes no digestibles; como los “probióticos”, microorganismos vivos; y los “simbióticos”, la combinación de ambos, son productos muy habituales en el mercado y su utilización está muy extendida en el campo de la nutrición animal. No obstante, los “posbióticos”, el miembro más novedoso de la familia de los compuestos bioactivos, aún no es muy conocido. Si bien los probióticos son generalmente las bacterias vivas que producen sustancias beneficiosas para la salud, los posbióticos consisten en las sustancias concretas generadas bajo determinadas condiciones (tabla). Así, los posbióticos son productos o subproductos metabólicos bioactivos, secretados por bacterias vivas o liberados a partir de la lisis de la membrana celular bacteriana, que pueden ser utilizados para mejorar la salud del hospedador. Los posbióticos pueden incluir metabolitos como enzimas, péptidos, proteínas, exopolisacáridos, ácidos orgánicos y lípidos, y componentes estructurales, fundamentalmente de la pared celular bacteriana, como ácidos teicoico y lipoteicoico, peptidoglicano, proteínas de la capa superficial bacteriana y otros polisacáridos. La gran potencialidad de los posbióticos en producción animal se atribuye debido a la gran variedad de los efectos de sus componentes, que pueden ser tanto locales, principalmente a nivel intestinal, como sistémico, mediante la acción reguladora de sus moléculas. No obstante, depende en gran medida de la cepa bacteriana que se utilice en su producción y de los tipos de compuestos bioactivos que produzcan, que en ocasiones son difíciles de cuantificar y caracterizar. El número de
Tabla. Definición de conceptos asociados a los compuestos bioactivos relacionados con los probióticos y sus derivados.
Concepto Definición Referencia
Prebiótico Ingredientes no digestibles de los alimentos que mejoran la salud del hospedador (FAO/OMS 2001; Wegh et al., 2019)
Probiótico
Microorganismos vivos que, administrados en cantidades adecuadas, confieren beneficios para la salud del hospedador (FAO/OMS 2001; Wegh et al., 2019)
Simbiótico Mezcla sinérgica de prebióticos y probióticos que mejoran la salud del hospedador Paraprobiótico Células de microorganismos probióticos inactivadas que confieren beneficios para la salud del hospedador Posbiótico Factores solubles generados del metabolismo de los probióticos que mejoran la salud del hospedador
(FAO/OMS 2001; Wegh et al., 2019) (Aguilar-Toalá et al., 2018; Wegh et al., 2019) (Aguilar-Toalá et al., 2018; Wegh et al., 2019)
Figura 3. Proceso de producción resumido de un pienso funcional con posbióticos y sus aplicaciones.
Posbiótico
Conservante de alimentos
Tratamiento de infecciones multirresistentes
Aplicaciones
Sinergia antibióticos
Suplementos alimentación animal
Terapia inmunomoduladora
nutrición
estudios en esta área es todavía muy limitado, por lo que es necesaria una mayor investigación, en especial en condiciones reales de campo (figura 3).
ALTERNATIVAS A LOS ANTIBIÓTICOS
Los antibióticos han sido desde su descubrimiento hasta hoy día los fármacos más eficaces contra las infecciones provocadas por microorganismos, pero su uso indiscriminado ha provocado numerosas reacciones adversas en la salud individual y comunitaria, tales como la aparición de bacterias resistentes o la destrucción de la microbiota del individuo debido a un tratamiento antibiótico, lo que acarrea alteraciones en la función normal del organismo. Las bacteriocinas presentes en los piensos funcionales son capaces de potenciar la actividad de los antibióticos, actuando conjuntamente sobre los microorganismos patógenos, consiguiendo un efecto sinérgico. Se entiende por sinergia, propiamente dicha, al aumento de actividad de dos compuestos usados conjuntamente en terapia sobre la actividad de cada uno de los compuestos usado por separado. El efecto que es logrado mediante una combinación sinérgica de dos compuestos es mayor a la que se podría esperar sumando los efectos por separado, esto puede ser debido a una mejora en sus cualidades farmacocinéticas, absorción y distribución del compuesto en el organismo, o farmacodinámicas, que hace referencia al mecanismo de acción de los compuestos. La sinergia que se produce entre bacteriocinas y antibióticos es una sinergia de tipo farmacodinámico de carácter funcional, en el que ambos compuestos actúan sobre diferentes estructuras bacterianas generando un acúmulo de consecuencias que potencian la acción entre sí mismas, lo que se traduce en un incremento de la actividad antimicrobiana. Las ventajas que conllevan el uso de las cualidades sinérgicas entre bacteriocinas y antibióticos son de una alta relevancia tanto en contexto sanitario como económico y productivo. Como consecuencia directa del uso de dos agentes sinérgicos en terapia está la reducción de las dosis usadas de cada uno de ellos. La producción de un antibiótico es un proceso complejo y costoso, frente a la producción de un posbiótico que es más sencilla al tratarse de un proceso de fermentación controlado, mucho más simple y económico. La reducción de las dosis de antibiótico supone un gran ahorro económico para su producción, pero además repercute positivamente en la salud individual y global. Los antibióticos tienen numerosos efectos adversos derivados de su propio mecanismo de acción, como es la destrucción de poblaciones bacterianas correspondientes a la propia microbiota, vitales para el correcto funcionamiento de la fisiología del hospedador. Las bacteriocinas producidas por especies bacterianas aisladas de la propia microbiota son moléculas que han surgido como fruto de la de la selección natural con el fin de defender el nicho del
Figura 4. Resistencias antimicrobianas en laboratorio.
que son habitualmente huéspedes, por ello son selectivas frente a microorganismos patógenos y no alteran las poblaciones de aquellos comensales que formen parte de la microbiota del hospedador. Por otro lado, las bacterias, como consecuencia de una presión evolutiva selectiva, desarrollan mecanismos de resistencia. Los mecanismos de resistencias microbianas son mutaciones en el material genético bacteriano que les confieren las cualidades necesarias para evadir la acción de un agente antimicrobiano. La disminución de la dosis requerida para alcanzar el efecto deseado reduce esta presión evolutiva sobre los microorganismos patógenos, lo cual se une a un aumento en la eficacia como fruto de la potenciación de la actividad antibacteriana entre ambos agentes sinérgicos, lo que conlleva una ralentización o reversión de la aparición de resistencias microbianas. Por tanto, supone una vía alternativa para hacer frente a la actual emergencia en salud global de encontrar tratamientos antimicrobianos eficaces y reducir la aparición de cepas patógenas resistentes a los antibióticos.
REFERENCIAS
Aguilar-Toalá, J. E., et al. “Postbiotics: An evolving term within the functional foods field.” Trends in Food Science & Technology 75 (2018): 105-114. Bajagai, Yadav S., et al. Probiotics in animal nutrition: production, impact and regulation. FAO, 2016. FAO, OMS. “Regulatory and clinical aspects of dairy probiotics.” FAO and OMS Expert Consultation Report. Working group Report (online) (2001). Mathur, Harsh, et al. “Bacteriocin-antimicrobial synergy: a medical and food perspective.” Frontiers in Microbiology 8 (2017): 1205. Piqué, Núria, Mercedes Berlanga and David MiñanaGalbis. “Health benefits of heat-killed (Tyndallized) probiotics: An overview.” International journal of molecular sciences 20.10 (2019): 2534. Wegh, Carrie AM, et al. “Postbiotics and their potential applications in early life nutrition and beyond.” International journal of molecular sciences 20.19 (2019): 4673.
